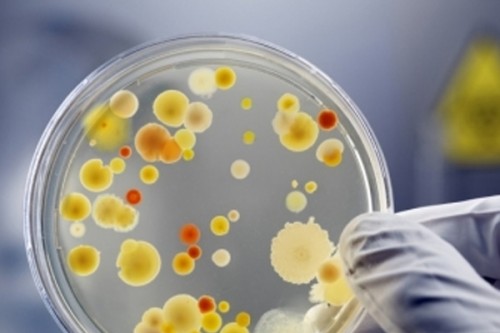

Curtailing pollution must to reduce superbugs: UN report
New Delhi, Feb 8 (IANS) Curtailing pollution created by pharmaceuticals, agricultural and healthcare sectors is essential to reduce the emergence, transmission, and spread of superbugs -- strains of bacteria that have become resistant to every known antibiotic -- and other instances of antimicrobial resistance, known as AMR.
This is the key message of a report released on Tuesday by the UN Environment Programme (UNEP) on the environmental dimensions of AMR, which already is taking a serious toll on the health of humans, animals, and plants, as well as the economy.
The report, 'Bracing for Superbugs: strengthening environmental action in the One Health response to antimicrobial resistance', was launched at the Sixth Meeting of the Global Leaders Group on AMR, held in Barbados.
It calls for a multisectoral One Health response. This is in line with the work of the Quadripartite Alliance, including UNEP, the Food and Agriculture Organization (FAO), the World Health Organization (WHO) and the World Organization for Animal Health (WOAH).
"The environmental crisis of our time is also one of human rights and geopolitics -- the antimicrobial resistance report published by UNEP today is yet another example of inequity, in that the AMR crisis is disproportionately affecting countries in the Global South countries," said Prime Minister Mia Amor Mottley, Chair of the One Health Global Leaders Group on Antimicrobial Resistance.
"We must remain focused on turning the tide in this crisis by raising awareness and by placing this matter of global importance on the agenda of the world's nations."
The development and spread of AMR mean that antimicrobials used to prevent and treat infections in humans, animals and plants might turn ineffective, with modern medicine no longer able to treat even mild infections.
Listed by the WHO among the top 10 global threats to health, it is estimated that in 2019, 1.27 million deaths were directly attributed to drug-resistant infections globally, and 4.95 million deaths worldwide were associated with bacterial AMR (including those directly attributable to AMR).
AMR is expected to cause 10 million additional direct deaths annually by 2050. This equals the number of deaths caused globally by cancer in 2020.
The economic toll of AMR is expected to result in a GDP drop of at least $3.4 trillion annually by 2030, pushing 24 million more people into extreme poverty.
The triple planetary crisis entails higher temperatures and extreme weather patterns, land-use changes that alter its microbial diversity, as well as biological and chemical pollution. All these contribute to the development and spread of AMR.
"Pollution of air, soil, and waterways undermines the human right to a clean and healthy environment. The same drivers that cause environment degradation are worsening the antimicrobial resistance problem. The impacts of anti-microbial resistance could destroy our health and food systems," said Inger Andersen, Executive Director of UNEP.
"Cutting down pollution is a prerequisite for another century of progress towards zero hunger and good health."
The report highlights a comprehensive set of measures to address both the decline of the environment and the rise of AMR, especially addressing key pollution sources from poor sanitation, sewage, community and municipal wastes.

|

|

